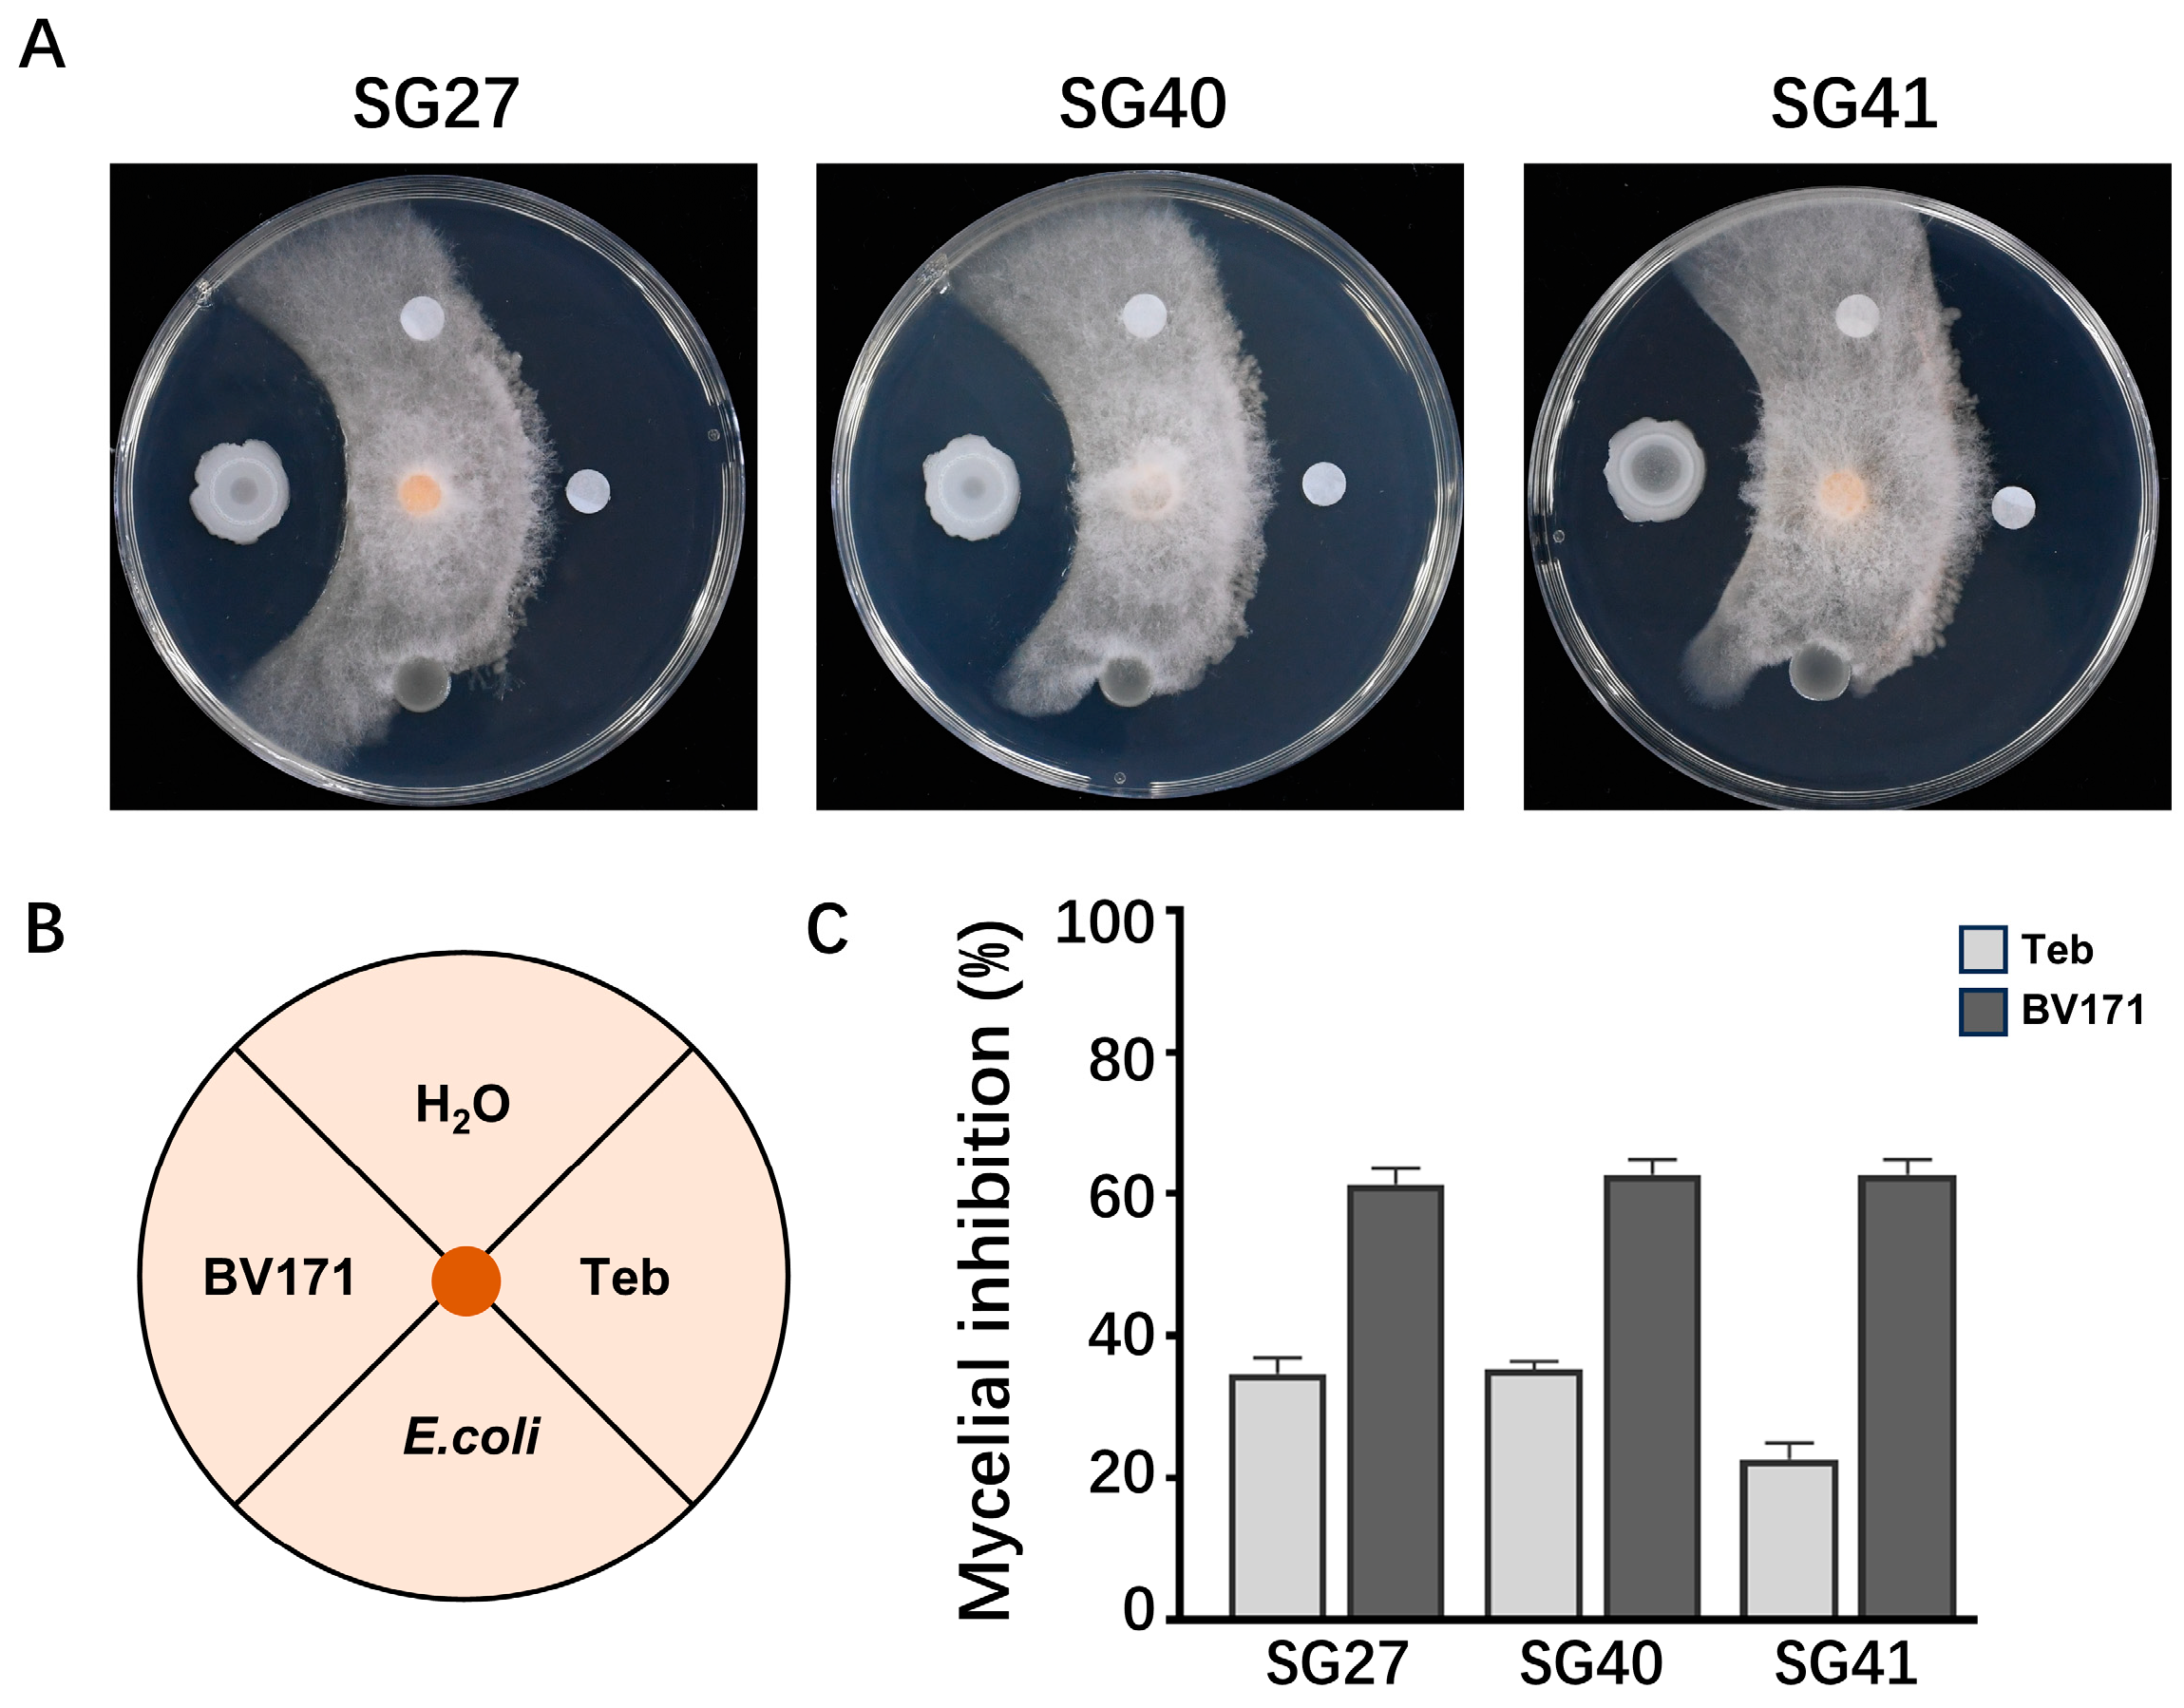
Plants 14 00845 g005

Identification and Characterization of Fusarium incarnatum Causing Leaf Spot and Fruit Rot on Luffa in China
Abstract
1. Introduction
2. Results
2.1. Sponge Gourd Rot Symptoms Caused by F. incarnatum
2.2. Fungal Isolation and Morphological Characterization
2.3. Pathogen Molecular Identification
2.4. Pathogenicity Test
2.5. Biological Control of F. incarnatum by Bacteria
3. Discussion
4. Materials and Methods
4.1. Pathogen Isolation and Purification
4.2. Pathogen Identification
4.3. Mycelia Growth, Conidiation and Morphological Characteristics
4.4. Pathogenicity Tests of Strains on Sponge Gourd Plants and Fruits
4.5. Determination of Antagonistic Activity
4.6. Data Analysis
5. Conclusions
Author Contributions
Funding
Data Availability Statement
Conflicts of Interest
References
- Pickford, C.; McCormack, L.; Liu, Y.; Eicher-Miller, H.A. Us Department of Agriculture Food Composition Databases, the Food and Nutrient Database for Dietary Studies 2013–2014, and the National Nutrient Database for Standard Reference Version 28 Yield Significantly Different Nutrient Totals of Food Items from Eight Midwestern Food Pantry Inventories. J. Acad. Nutr. Diet. 2022, 122, 1326. [Google Scholar] [CrossRef]
- Akinyemi, B.A.; Dai, C. Luffa cylindrical Fibre as: An Emerging Natural Reinforcement Fibre for Cement Composites Reinforcement—A Review. J. Sustain Cem. Based 2022, 11, 297–307. [Google Scholar] [CrossRef]
- Adetoyese, A.O.; Aransiola, E.F.; Ademakinwa, N.A.; Bada, B.S.; Agboola, F.K. Optimization Study of Bioethanol Production from Sponge Gourd (Luffa cylindrica). Sci. Afr. 2020, 8, e00407. [Google Scholar] [CrossRef]
- Arise, R.O.; Idi, J.J.; Mic-Braimoh, I.M.; Korode, E.; Ahmed, R.N.; Osemwegie, O. In Vitro Angiotesin-1-Converting Enzyme, A-Amylase and A-Glucosidase Inhibitory and Antioxidant Activities of Luffa cylindrical (L.) M. Roem Seed Protein Hydrolysate. Heliyon 2019, 5, e1634. [Google Scholar] [CrossRef] [PubMed]
- Abdel-Salam, I.M.; Awadein, N.E.; Ashour, M. Cytotoxicity of Luffa Cylindrica (L.) M. Roem. Extract Against Circulating Cancer Stem Cells in Hepatocellular carcinoma. J. Ethnopharmacol. 2019, 229, 89–96. [Google Scholar] [CrossRef]
- Abdel-Salam, I.M.; Abou-Bakr, A.A.; Ashour, M. Cytotoxic Effect of Aqueous Ethanolic Extract of Luffa Cylindrica Leaves on Cancer Stem Cells Cd44+/24− in Breast Cancer Patients with Various Molecular Sub-Types Using Tissue Samples in Vitro. J. Ethnopharmacol. 2019, 28, 238. [Google Scholar] [CrossRef] [PubMed]
- Khajuria, A.; Gupta, A.; Garai, S.; Wakhloo, B.P. Immunomodulatory Effects of Two Sapogenins 1 and 2 Isolated from Luffa cylindrica in Balb/C Mice. Bioorg. Med. Chem. Lett. 2007, 17, 1608–1612. [Google Scholar] [CrossRef]
- Namisy, A.; Huang, J.; Rakha, M.; Hong, C.; Chung, W. Resistance to Fusarium oxysporum f. sp. Luffae in Luffa Germplasm Despite Hypocotyl Colonization. Plant Dis. 2023, 107, 1993–2001. [Google Scholar] [CrossRef]
- Li, P.; Zhu, J.Z.; Li, X.G.; Zhong, J. Identification and Characterization of Colletotrichum fructicola and Colletotrichum siamense Causing Anthracnose on Luffa Sponge Gourd in China. Plants 2022, 11, 1537. [Google Scholar] [CrossRef]
- Rauf, M.; Ur-Rahman, A.; Arif, M.; Gul, H.; Ud-Din, A.; Hamayun, M.; Lee, I. Immunomodulatory Molecular Mechanisms of Luffa cylindrica for Downy Mildews Resistance Induced by Growth-Promoting Endophytic Fungi. J. Fungi 2022, 8, 689. [Google Scholar] [CrossRef]
- Yu, X.Y.; Li, Z.H.; Zhang, J.; Guo, L.F.; Wang, X.J.; Zhao, J.W.; Xiang, W.S. First Report of Alternaria tenuissima Causing Leaf Spot on Luffa cylindrica in China. Plant Dis. 2023, 107, 231. [Google Scholar] [CrossRef]
- Siddiqui, Z.S.; Habib, A.; Umar, M.; Shams, Z.I. Effect of Pythium aphanidermatum (Root Rot Pathogen) on the Physiology of Luffa Cylindrica (Sponge Gourd) and its Management by Microbial Antagonists. S. Afr. J. Bot. 2022, 146, 614–623. [Google Scholar] [CrossRef]
- Abdel-Kader, M.M.; Khalil, M.S.A.; El-Gamal, N.G.; El-Mougy, N.S. Management of Fusarium Fruit Rot of Luffa Cylindrical Caused by Fusarium incarnatum and Fusarium chlamydosporum. Eur. J. Plant Pathol. 2024, 169, 233–245. [Google Scholar] [CrossRef]
- Ma, L.; Geiser, D.M.; Proctor, R.H.; Rooney, A.P.; O’Donnell, K.; Trail, F.; Gardiner, D.M.; Manners, J.M.; Kazan, K. Fusarium Pathogenomics. Annu. Rev. Microbiol. 2013, 67, 399–416. [Google Scholar] [CrossRef] [PubMed]
- Din, H.M.; Rashed, O.; Ahmad, K. Prevalence of Fusarium Wilt Disease of Cucumber (Cucumis sativus Linn) in Peninsular Malaysia Caused by Fusarium oxysporum and F. solani. Trop Life Sci. Res. 2020, 31, 29–45. [Google Scholar] [CrossRef]
- Gao, X.M.; Li, K.; Ma, Z.L.; Zou, H.F.; Jin, H.; Wang, J.G. Cucumber Fusarium Wilt Resistance Induced by Intercropping with Celery Differs from that Induced by the Cucumber Genotype and is Related to Sulfur-Containing Allelochemicals. Sci. Hortic. 2020, 271, 109475. [Google Scholar] [CrossRef]
- Vakalounakis, D.J.; Doulis, A.G.; Klironomou, E. Characterization of Fusarium oxysporum f. sp Radicis-Cucumerinum Attacking Melon Under Natural Conditions in Greece. Plant Pathol. 2005, 54, 339–346. [Google Scholar] [CrossRef]
- Sabahi, F.; Banihashemi, Z.; Mirtalebi, M.; Rep, M.; Cacciola, S.O. Molecular Variability of the Fusarium solani Species Complex Associated with Fusarium Wilt of Melon in Iran. J. Fungi 2023, 9, 486. [Google Scholar] [CrossRef]
- Intana, W.; Kheawleng, S.; Sunpapao, A. Trichoderma asperellum T76-14 Released Volatile Organic Compounds Against Postharvest Fruit Rot in Muskmelons (Cucumis melo) Caused by Fusarium incarnatum. J. Fungi 2021, 7, 46. [Google Scholar] [CrossRef]
- Garcia-Estrada, R.S.; Marquez-Zequera, I.; Tovar-Pedraza, J.M.; Cruz-Lachica, I. First Report of Cucumber Fruit Rot Caused by Fusarium incarnatum in Mexico. Plant Dis. 2021, 105, 497. [Google Scholar] [CrossRef]
- Zhang, L.Q.; Su, M.S.; Zhou, J.Y.; Zhao, T.; Du, J.H.; Li, X.W.; Ye, Z.W. First Report of Fusarium incarnatum-equiseti Species Complex Causing Fruit Rot of Peach (Prunus persica) in China. Plant Dis. 2020, 104, 1872. [Google Scholar] [CrossRef]
- Tariq, A.; Naz, F.; Altaf, R.; Jabeen, Z.; Rauf, C.A.; Irshad, G.; Raja, M.U.; Shaheen, F.A.; Sultana, T.; Aslam, M.; et al. First Report of Fruit Rot of Bell Pepper Caused by Fusarium incarnatum in Pakistan. Plant Dis. 2018, 102, 2645–2646. [Google Scholar] [CrossRef]
- Zhu, X.Q.; Liu, D.M.; Hong, Q.C.; Lu, Y.F.; Pei, D.L. First Report of Chili Pepper Fruit Rot Caused by Fusarium incarnatum in China. Plant Dis. 2021, 105, 3304. [Google Scholar] [CrossRef] [PubMed]
- Li, Z.H.; Yu, X.Y.; Zhang, W.Q.; Han, R.; Zhang, J.; Ma, Y.; Guo, L.F.; Wang, X.J.; Zhao, J.W.; Xiang, W.S. Identification, Characterization, and Pathogenicity of Fungi Associated with Strawberry Fruit Rot in Shandong Province, China. Plant Dis. 2023, 107, 3773–3782. [Google Scholar] [CrossRef] [PubMed]
- Gao, Z.Y.; Wang, J.B.; Zhang, Z.K.; Li, M.; Gong, D.Q.; Hong, X.Y.; Li, H.L.; Wang, Y.; Zhao, C.; Hu, M.J. First Report of Fusarium incarnatum Causing Fruit Rot of Litchi in China. Plant Dis. 2021, 105, 1943–7692. [Google Scholar] [CrossRef] [PubMed]
- Mulk, S.; Wahab, A.; Yasmin, H.; Mumtaz, S.; El-Serehy, H.A.; Khan, N.; Hassan, M.N. Prevalence of Wheat Associated Bacillus spp. And their Bio-Control Efficacy Against Fusarium Root Rot. Front. Microbiol. 2022, 12, 798619. [Google Scholar] [CrossRef]
- Fan, H.C.; He, P.; Xu, S.T.; Li, S.; Wang, Y.F.; Zhang, W.L.; Li, X.D.; Shang, H.; Zeng, L.; Zheng, S.J. Banana Disease-Suppressive Soil Drives Bacillus Assembled to Defense Fusarium Wilt of Banana. Front. Microbiol. 2023, 14, 1211301. [Google Scholar] [CrossRef]
- Izquierdo-Garcia, L.F.; Carmona-Gutierrez, S.L.; Moreno-Velandia, C.A.; Villarreal-Navarrete, A.D.P.; Burbano-David, D.M.; Quiroga-Mateus, R.Y.; Gomez-Marroquin, M.R.; Rodriguez-Yzquierdo, G.A.; Betancourt-Vasquez, M. Microbial-Based Biofungicides Mitigate the Damage Caused by Fusarium oxysporum f. sp. cubense Race 1 and Improve the Physiological Performance in Banana. J. Fungi 2024, 10, 419. [Google Scholar] [CrossRef]
- Ma, J.N.; Gao, C.; Lin, M.W.; Sun, Z.Z.; Zhao, Y.H.; Li, X.; Zhao, T.Y.; Xu, X.G.; Sun, W.H. Control of Fusarium Head Blight of Wheat with Bacillus velezensis E2 and Potential Mechanisms of Action. J. Fungi 2024, 10, 390. [Google Scholar] [CrossRef]
- Zanon, M.S.A.; Cavaglieri, L.R.; Palazzini, J.M.; Chulze, S.N.; Chiotta, M.L. Bacillus velezensis RC218 and Emerging Biocontrol Agents Against Fusarium graminearum and Fusarium poae in Barley: In Vitro, Greenhouse and Field Conditions. Int. J. Food Microbiol. 2024, 413, 110580. [Google Scholar] [CrossRef]
- Valenzuela-Aragon, B.; Montoya-Martinez, A.C.; Parra-Cota, F.I.; de Los Santos-villalobos, S. Genomic Insight into a Potential Biological Control Agent for Fusarium -Related Diseases in Potatoes: Bacillus cabrialesii Subsp. cabrialesii Strain PE1. Horticulturae 2024, 10, 357. [Google Scholar] [CrossRef]
- Wang, M.M.; Chen, Q.; Diao, Y.Z.; Duan, W.J.; Cai, L. Fusarium incarnatum-equiseti Complex from China. Persoonia Mol. Phylogenet. Evol. 2019, 43, 70–89. [Google Scholar] [CrossRef] [PubMed]
- Vakalounakis, D.J.; Wang, Z.; Fragkiadakis, G.A.; Skaracis, G.N.; Li, D.B. Characterization of Fusarium oxysporum Isolates Obtained from Cucumber in China by Pathogenicity, Vcg, and Rapd. Plant Dis. 2004, 88, 645–649. [Google Scholar] [CrossRef]
- Li, B.J.; Li, H.L.; Shi, Y.X.; Xie, X.W. First Report of Pseudomonas Cichorii Causing Leaf Spot of Vegetable Sponge Gourd in China. Plant Dis. 2014, 98, 153. [Google Scholar] [CrossRef]
- Liu, J.X.; Cai, Y.N.; Jiang, W.Y.; Li, Y.G.; Zhang, Q.F.; Pan, H.Y. Population Structure and Genetic Diversity of Fungi Causing Rice Seedling Blight in Northeast China Based on Microsatellite Markers. Plant Dis. 2020, 104, 868–874. [Google Scholar] [CrossRef]
- Qiu, J.B.; Gu, H.; Wang, S.F.; Ji, F.; He, C.; Jiang, C.; Shi, J.R.; Liu, X.; Shen, G.H.; Lee, Y.; et al. A Diverse Fusarium Community is Responsible for Contamination of Rice with a Variety of Fusarium Toxins. Food Res. Int. 2024, 195, 114987. [Google Scholar] [CrossRef] [PubMed]
- Liu, J.X.; Han, Y.J.; Li, W.Q.; Qi, T.C.; Zhang, J.M.; Li, Y.G. Identification of Pathogens and Evaluation of Resistance and Genetic Diversity of Maize Inbred Lines to Stalk Rot in Heilongjiang Province, China. Plant Dis. 2023, 107, 288–297. [Google Scholar] [CrossRef]
- Zhang, X.X.; Sun, H.Y.; Shen, C.M.; Li, W.; Yu, H.S.; Chen, H.G. Survey of Fusarium spp. Causing Wheat Crown Rot in Major Winter Wheat Growing Regions of China. Plant Dis. 2015, 99, 1610–1615. [Google Scholar] [CrossRef]
- Mao, Y.S.; Zhang, Y.; Zhou, M.G.; Duan, Y.B. Occurrence of Crown Rot Disease Caused by Fusarium incarnatum on Cucumber (Cucumis sativus) in China. Plant Dis. 2020, 104, 593–594. [Google Scholar] [CrossRef]
- Ye, Q.J.; Wang, R.Q.; Ruan, M.Y.; Yao, Z.P.; Cheng, Y.; Wan, H.J.; Li, Z.M.; Yang, Y.J.; Zhou, G.Z. Genetic Diversity and Identification of Wilt and Root Rot Pathogens of Tomato in China. Plant Dis. 2020, 104, 1715–1724. [Google Scholar] [CrossRef]
- Lou, J.; Wang, J.J.; Zeng, S.S.; Xiong, X.H.; Guo, M.M.; Li, D.Y.; Song, F.M. The Secreted Protein FonCHRD is Essential for Vegetative Growth, Asexual Reproduction, and Pathogenicity in Watermelon Fusarium Wilt Fungus. Crop Health 2024, 2, 16. [Google Scholar] [CrossRef]
- Besharati Fard, M.; Mohammadi, A.; Darvishnia, M. Fusarium Species Associated with Wheat Crown and Root Tissues in the Eastern Iran. Arch. Phytopathol. Plant Prot. 2017, 50, 123–133. [Google Scholar] [CrossRef]
- Motallebi, P.; Niknam, V.; Ebrahimzadeh, H.; Hashemi, M.; Pisi, A.; Prodi, A.; Tonti, S.; Nipoti, P. Methyl Jasmonate Strengthens Wheat Plants Against Root and Crown Rot Pathogen Fusarium culmorum Infection. J. Plant Growth Regul. 2015, 34, 624–636. [Google Scholar] [CrossRef]
- Dehghanpour-Farashah, S.; Taheri, P.; Falahati-Rastegar, M. Identification and Pathogenicity of Fusarium spp., The Causal Agent of Wheat Crown and Root Rot in Iran. J. Plant Pathol. 2020, 102, 143–154. [Google Scholar] [CrossRef]
- Lu, Y.A.; Qiu, J.B.; Wang, S.F.; Xu, J.H.; Ma, G.Z.; Shi, J.R.; Bao, Z.H. Species Diversity and Toxigenic Potential of Fusarium incarnatum-equiseti Species Complex Isolates from Rice and Soybean in China. Plant Dis. 2021, 105, 2628–2636. [Google Scholar] [CrossRef]
- Gai, X.T.; Yang, R.X.; Pan, X.J.; Yuan, Y.; Wang, S.N.; Liang, B.B.; Gao, Z.G. First Report of Fusarium incarnatum Causing Stalk Rot on Maize in China. Plant Dis. 2016, 100, 1010. [Google Scholar] [CrossRef]
- Ma, G.P.; Wang, H.; Qi, K.; Ma, L.G.; Zhang, B.; Zhang, Y.L.; Jiang, H.; Wu, X.H.; Qi, J.S. Isolation, Characterization, and Pathogenicity of Fusarium Species Causing Crown Rot of Wheat. Front. Microbiol. 2024, 15, 1405115. [Google Scholar] [CrossRef]
- Gao, X.L.; Wang, Y.H.; Liu, Y.; Zhang, M.; Zhang, W.H.; Li, Y.T. First Report of Leaf Spot on Cucumber Caused by Fusarium incarnatum in China. Plant Dis. 2020, 104, 973. [Google Scholar] [CrossRef]
- Cao, P.; Li, C.; Xiang, W.; Wang, X.; Zhao, J. First Report of Fusarium incarnatum–equiseti Species Complex Causing Fruit Rot on Muskmelon (Cucumis melo) in China. Plant Dis. 2019, 103, 1768–1769. [Google Scholar] [CrossRef]
- Wang, C.; Yin, J.; Li, Y.; Li, J.; Zhang, R.; Wang, X.; Shan, H.; Luo, Z. Multi-Gene Identification and Pathogenicity Analysis of Sugarcane Pokkah Boeng Disease Pathogens in Yunnan, China. Trop. Plant Biol. 2024, 17, 296–305. [Google Scholar] [CrossRef]
- Du, L.F.; Zeng, Q.; Xu, J.; Zhang, S.Y.; Yu, G.X.; Guo, T.R.; Mo, Y.W. Identification, biological characteristics and indoor fungicide selection of Fusarium incarnatum in Hami melo. J. Fruit Sci. 2022, 39, 855–869. [Google Scholar] [CrossRef]
- Zhang, J.Y.; Zhao, Z.Y.; Liang, W.Y.; Bi, J.Y.; Zheng, Y.G.; Gu, X.; Fang, H.Y. Essential Oil from Sabina Chinensis Leaves: A Promising Green Control Agent Against Fusarium sp. Front. Plant Sci. 2022, 13, 1006303. [Google Scholar] [CrossRef] [PubMed]
- Mao, Y.S.; Zhao, B.Q.; Cao, Z.G.; Shen, J.H.; Xu, S.H.; Wu, J.; Li, T.; Wang, J.X.; Statsyuk, N.; Shcherbakova, L.; et al. Risk Assessment and Molecular Mechanism of Fusarium incarnatum Resistance to Phenamacril. Pest Manag. Sci. 2022, 78, 3394–3403. [Google Scholar] [CrossRef]
- Song, M.; Yun, H.Y.; Kim, Y.H. Antagonistic Bacillus Species as a Biological Control of Ginseng Root Rot Caused by Fusarium cf. incarnatum. J. Ginseng Res. 2014, 38, 136–145. [Google Scholar] [CrossRef]
- Liu, J.X.; Qin, D.; Huang, W.; Wang, X.Q.; Li, Y.G.; Zhang, R. Biocontrol Ability and Action Mechanism of Bacillus amyloliquefaciens Baf1 Against Fusarium incarnatum Causing Fruit Rot in Postharvest Muskmelon (Cv. Yugu) Fruit. LWT-Food Sci. Technol. 2023, 181, 114714. [Google Scholar] [CrossRef]
- Ran, J.J.; Wu, Y.Z.; Zhang, B.; Su, Y.W.; Lu, N.H.; Li, Y.C.; Liang, X.H.; Zhou, H.X.; Shi, J.R. Paenibacillus polymyxa Antagonism Towards Fusarium: Identification and Optimisation of Antibiotic Production. Toxins 2023, 15, 138. [Google Scholar] [CrossRef]
- Noman, M.; Ahmed, T.; Wang, J.Y.; Ijaz, M.; Shahid, M.; Islam, M.S.; Azizullah; Manzoor, I.; Li, D.Y.; Song, F.M. Nano-Enabled Crop Resilience Against Pathogens: Potential, Mechanisms and Strategies. Crop Health. 2023, 1, 15. [Google Scholar] [CrossRef]
- Mishra, P.K.; Fox, R.; Culham, A. Development of a PCR-Based Assay for Rapid and Reliable Identification of Pathogenic Fusaria. FEMS Microbiol. Lett. 2003, 218, 329–332. [Google Scholar] [CrossRef]
- Zarrin, M.; Ganj, F.; Faramarzi, S. Analysis of the rDNA Internal Transcribed Spacer Region of the Fusarium Species by Polymerase Chain Reaction-Restriction Fragment Length Polymorphism. Biomed. Rep. 2016, 4, 471–474. [Google Scholar] [CrossRef]
- Stumpf, R.; Santos, J.D.; Gomes, L.B.; Silva, C.N.; Tessmann, D.J.; Ferreira, F.D.; Junior, M.M.; Ponte, E.M.D. Fusarium Species and Fumonisins Associated with Maize Kernels Produced in Rio Grande Do Sul State for the 2008/09 and 2009/10 Growing Seasons. Braz. J. Microbiol. 2013, 44, 89–95. [Google Scholar] [CrossRef]
- Liu, Y.; Whelen, S.; Benjamin, D.H. Phylogenetic Relationships Among Ascomycetes: Evidence from an RNA Polymerase II Subunit. Mol. Biol. Evol. 1999, 16, 1799–1808. [Google Scholar] [CrossRef] [PubMed]
- Sung, G.; Sung, J.; Hywel-Jones, N.L.; Spatafora, J.W. A Multi-Gene Phylogeny of Clavicipitaceae (Ascomycota, Fungi): Identification of Localized Incongruence Using a Combinational Bootstrap Approach. Mol. Phylogenet. Evol. 2007, 44, 1204–1223. [Google Scholar] [CrossRef] [PubMed]

Disclaimer/Publisher’s Note: The statements, opinions and data contained in all publications are solely those of the individual author(s) and contributor(s) and not of MDPI and/or the editor(s). MDPI and/or the editor(s) disclaim responsibility for any injury to people or property resulting from any ideas, methods, instructions or products referred to in the content. |
© 2025 by the authors. Licensee MDPI, Basel, Switzerland. This article is an open access article distributed under the terms and conditions of the Creative Commons Attribution (CC BY) license (https://creativecommons.org/licenses/by/4.0/).
Share and Cite
Chen, X.; Liu, H.; Dong, L.; Shi, J.; Ma, Z.; Yan, L.; Yin, Y. Identification and Characterization of Fusarium incarnatum Causing Leaf Spot and Fruit Rot on Luffa in China. Plants 2025, 14, 845. https://doi.org/10.3390/plants14060845
Chen X, Liu H, Dong L, Shi J, Ma Z, Yan L, Yin Y. Identification and Characterization of Fusarium incarnatum Causing Leaf Spot and Fruit Rot on Luffa in China. Plants. 2025; 14(6):845. https://doi.org/10.3390/plants14060845
Chicago/Turabian StyleChen, Xia, Hao Liu, Lanlan Dong, Junrui Shi, Zhonghua Ma, Leiyan Yan, and Yanni Yin. 2025. "Identification and Characterization of Fusarium incarnatum Causing Leaf Spot and Fruit Rot on Luffa in China" Plants 14, no. 6: 845. https://doi.org/10.3390/plants14060845
APA StyleChen, X., Liu, H., Dong, L., Shi, J., Ma, Z., Yan, L., & Yin, Y. (2025). Identification and Characterization of Fusarium incarnatum Causing Leaf Spot and Fruit Rot on Luffa in China. Plants, 14(6), 845. https://doi.org/10.3390/plants14060845

